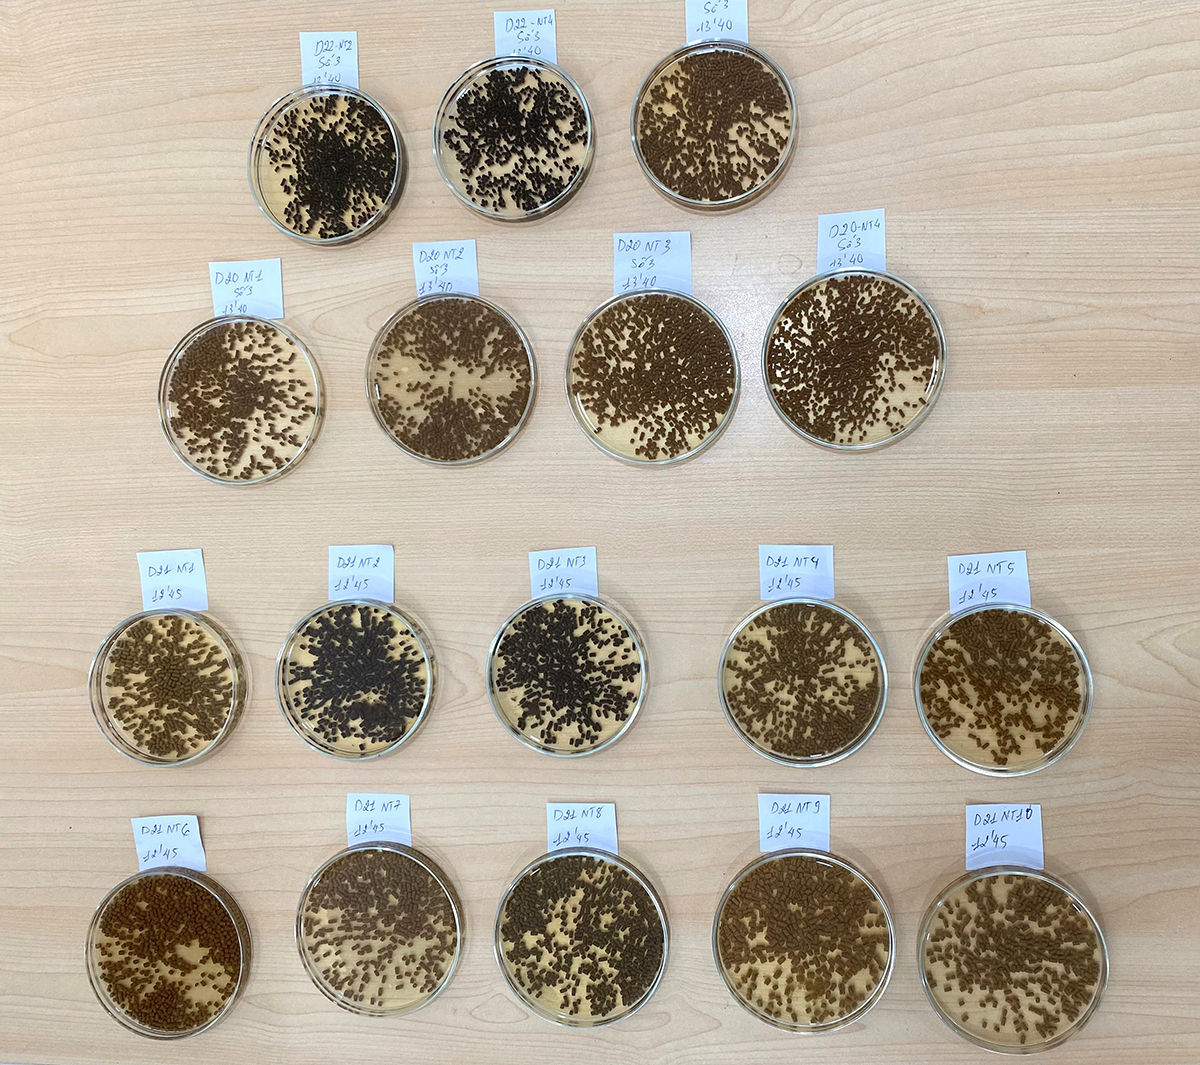

Viet-Uc and CSIRO collaboration demonstrates that the product outperformed a control diet in both shrimp growth and survival

Viet-Uc Seafood Corporation (Viet-Uc) is an important shrimp aquaculture company with involvement in the whole production value chain and is particularly dominant in the production of postlarvae of Pacific white shrimp (Litopenaeus vannamei) in Vietnam.
Over the last seven years, Viet-Uc has developed aquaculture nutrition capability to develop sustainable shrimp feeds. Central to this strategy is NovacqTM, a microbial biomass additive developed by Australia’s Commonwealth Scientific and Industrial Research Organisation (CSIRO) that enhances shrimp growth, feed efficiency and overall health. Novacq was produced and assessed in Vietnam by Viet Uc.
Since 2017, Viet-Uc and the CSIRO Aquaculture Nutrition and Production Systems group have been collaborating with Viet-Uc to understand the efficacy of this additive in L. vannamei nutrition. Until then, most of the published research on its efficacy relates to studies on black tiger shrimp (Penaeus monodon). Its effect across various life stages (e.g., postlarvae, juvenile and broodstock) and feed formulations (e.g., plant-based, low protein and low marine-origin ingredients) through its application as a strategic feed additive has shown improvements in feed intake, nutrient retention efficiencies, digestive physiology (e.g., nutrient absorption, gut transit microbiome) and immune response.
Most shrimp nutrition research is constrained, as experiments are conducted in small tanks over short periods (e.g., six weeks) in clear water and controlled conditions to ensure the results only reflect dietary treatments. However, the findings from these experiments do not always translate to commercial environments due to the large differences in culture conditions and farming practices. To help address these deficiencies, pilot-scale systems were developed to obtain more commercially relevant results whereby the effect of diets could be assessed throughout a harvest cycle (post-larvae to harvest size over a period of 13 weeks) and in larger culture systems (7-cubic-meter cement raceways). Use of pilot trials enables our research to investigate the efficacy of additives like Novacq™ under conditions that better mimic commercial conditions.
This article reports on the results of several years of research into the efficacy of Viet-Uc-produced Novacq when fed to L. vannamei shrimp using both small experimental tank and pilot-scale trials, with a focus on fostering industry adoption.
Viet-Uc nutrition facilities
The nutrition research at Viet-Uc is carried out at the Ba Tri shrimp hatchery in Ben Tre province, Vietnam. The research facilities and experimental protocols were developed in collaboration with the CSIRO Aquaculture Nutrition and Production Systems group to ensure that the research was scientifically robust and conducted to a high standard.
Commercial microbial biomass additive evaluated in black tiger shrimp diets
Experimental feed manufacturing
A feed manufacturing laboratory was established to manufacture feeds for both the small-tank (2 kg per treatment) and pilot-scale trials (250 kg per treatment, of various sizes, see Table 1 for details).
Rombenso, Novacq, Table 1
| Feed type | Feed size (mm) |
|---|---|
| Feed No. 0 (PL10 > PL18) | Fine crumble (0.1–0.3) |
| Feed No. 1 (PL18 > PL28) | Crumble (0.3–0.7) |
| Feed No. 2 (PL28 > 1g) | Crumble (0.7–1.0) |
| Feed No. 3 (1g > 4g) | Pellet (1.2) |
| Feed No. 4 (4g > 12g) | Pellet (1.5) |
| Feed No. 5 (12g > 20g) | Pellet (1.8) |
Small-tank and pilot-scale trials

An experimental system was constructed to enable the testing of many diets (15-40+) with high replication (five to eight tanks). For each experiment, this system is stocked with juvenile shrimp ranging from 0.35 to 0.55 grams at a stocking density of 10 animals per tank (30 liters) for six weeks. Water quality is maintained within the optimum ranges for the species with a flow-through of one exchange per hour, with a water temperature of 28–29 degrees-C. Shrimp are fed to slight excess six times (two times hand-feed and four times using an auto feeder) a day, seven days a week throughout the experiment. For more details on the experimental design, please see our peer-reviewed publication.
Pilot-scale trials are used to validate the findings from the juvenile trials and compare diet performance with commercial diets. The trials are conducted in rooms that each house 20 tanks of 7 cubic meters, where postlarvae-12 are stocked from 1,000 to 2,300 animals per tank (stocking densities 150–300 shrimp per square meter). Animals were hand-fed five times a day, seven days a week for 91 days. Water quality parameters, including ammonia, carbonate hardness, pH, salinity, dissolved oxygen and temperature, are measured regularly. Water is exchanged to maintain those parameters within the optimum range for the species. Upon completion of the trial, 100 shrimp per replicate are individually weighed and 50 shrimp of those are submitted to a coloration assessment, both before and after cooking. The remaining animals are individually counted and bulk-weighed.

Novacq efficacy meta-analysis
The results of trials conducted in both small and pilot-scale tanks completed in the last years were compiled to evaluate the efficacy of feeding the additive compared to a control for L. vannamei. All data were submitted to statistical meta-analyses of means using SPSS, an approach that has been underutilized by the aquaculture industry to validate products.
In small-tank trials, Novacq repeatedly outperformed the control diet resulting in larger animals (an average of 4 grams) and 25 percent greater survival rates, with one exception (Fig. 1). It is worthwhile mentioning that animals fed this additive also outperformed those fed a benchmark commercial feed (Fig. 2).


In pilot trials, similar Novacq efficacy responses were observed, whereby the product again outperformed the control in terms of survival, final biomass and feed conversion ratio (Fig. 3).

Ongoing research
Currently, there are several small-tank and pilot-scale experiments in progress that are assessing the following areas: ingredient quality and feed additive efficacy, inclusion rates, digestibility, feed formulation, feeding management and final product quality. Significant to this research effort is the development of novel tools to measure ingredient and diet composition and efficacy.
Perspectives
The Viet-Uc and CSIRO collaboration is a partnership between a private aquaculture company and a research agency that is accelerating the adoption of research outcomes by industry. Research completed using both controlled laboratory conditions and at pilot scale enables more confidence in the application of research outputs on an industrial scale. This is relevant for the many feed mills in Vietnam that are testing and validating formulations and feeds.
References available from the corresponding author.
Now that you've reached the end of the article ...
… please consider supporting GSA’s mission to advance responsible seafood practices through education, advocacy and third-party assurances. The Advocate aims to document the evolution of responsible seafood practices and share the expansive knowledge of our vast network of contributors.
By becoming a Global Seafood Alliance member, you’re ensuring that all of the pre-competitive work we do through member benefits, resources and events can continue. Individual membership costs just $50 a year.
Not a GSA member? Join us.
Authors
-

Artur Rombenso, Ph.D.
Corresponding author
Senior Research Scientist and Team Leader – Animal Nutrition
CSIRO Livestock & Aquaculture Program
Bribie Island Research Centre, 144 North St, Woorim, QLD 4507 AUS[117,97,46,111,114,105,115,99,64,111,115,110,101,98,109,111,114,46,114,117,116,114,97]
-
Minh Hoang Duong
Aquaculture nutritionist
Viet-Uc Seafood Corporation
Ben Nghe Ward, District 1, Ho Chi Minh City, Viet Nam -
Barney Hines
Research Technician – Animal Nutrition
CSIRO Livestock & Aquaculture Program
Queensland Bioscience Precinct, 306 Carmody Road, St Lucia, QLD 4067 AUS -
Le Thi Cam Nhung
Deputy
Viet-Uc Seafood Corporation
Ben Nghe Ward, District 1, Ho Chi Minh City, Viet Nam -
Ha Truong, Ph.D.
Research Scientist – Animal Nutrition
CSIRO Livestock & Aquaculture Program
Bribie Island Research Centre, 144 North St, Woorim, QLD 4507 AUS -
Nicholas Bourne
Research Technician – Animal Nutrition
CSIRO Livestock & Aquaculture Program
Queensland Bioscience Precinct, 306 Carmody Road, St Lucia, QLD 4067 AUS -
Tùng Mã
Chief Technology Development Officer
Viet-Uc Seafood Corporation
Ben Nghe Ward, District 1, Ho Chi Minh City, Viet Nam -
Cedric Simon, Ph.D.
Principal Research Scientist and Group Leader – Aquaculture Nutrition & Production Systems
CSIRO Livestock & Aquaculture Program
Queensland Bioscience Precinct, 306 Carmody Road, St. Lucia, QLD 4067 AUS
Tagged With
Related Posts

Innovation & Investment
Collaboration drives innovations in super-intensive indoor shrimp farming
A collaboration between Viet-Uc Seafood Corporation and CSIRO of Australia develops improvements in super-intensive indoor shrimp farming technology.

Innovation & Investment
Collaboration drives innovations in super-intensive indoor shrimp farming, part 2
Super-intensive production system with a whole-of-system approach shows substantial production, economic improvements at Viet Uc shrimp farm in Vietnam.

Aquafeeds
Commercial microbial biomass additive evaluated in black tiger shrimp diets
Initial insights on the effects of the commercial marine microbial biomass Novacq as an additive in feeds for black tiger shrimp postlarvae and juveniles.

Health & Welfare
Reduced growth performance of black tiger shrimp infected with IHHNV
This study simulated the commercial grow-out of two cohorts of P. monodon that differed in their broodstock IHHNV infection loads, and showed that the viral prevalence, survival and growth performance of pond progeny were significantly affected.



